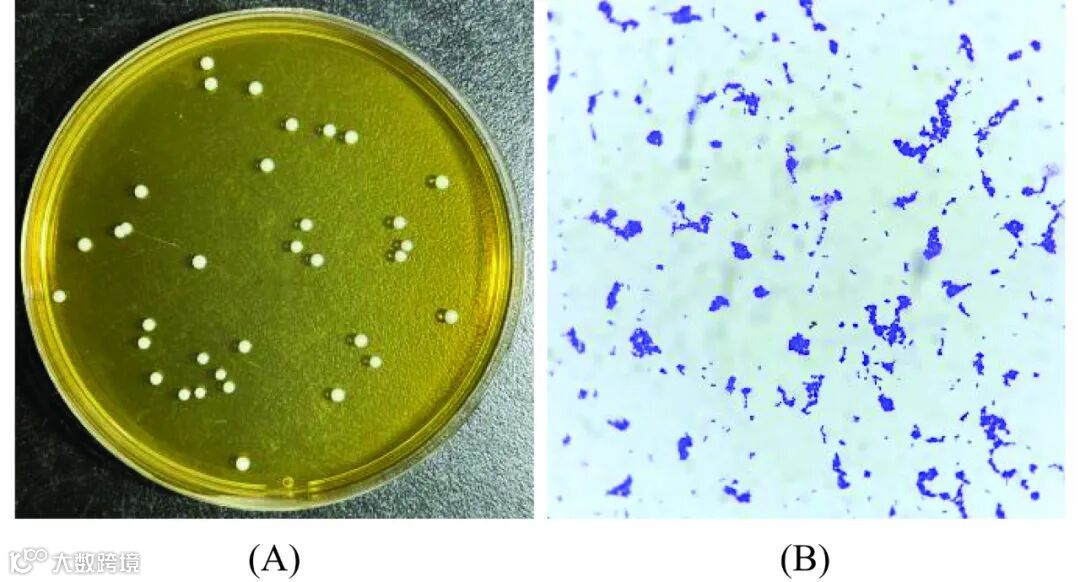

EI收录,
入选中国科技期刊卓越行动计划

本文获2025年国家级大学生创新创业训练计划(X2025103070364)。


图 1 不同乳酸菌株降解肌苷(A)和鸟苷(B)能力比较
Figure 1. Comparison of the ability of different lactic acid strains to degrade inosine (A) and guanosine (B)

图 2 模拟肠液消化耐受能力
Figure 2. Tolerance to simulated intestinal fluid digestion
注:不同小写字母表示数据间有显著差异(P<0.05),图3、图6同。

图 3 四株乳酸菌细胞黏附能力的差异
Figure 3. Differences in cell adhesion ability among four strains of lactic acid bacteria
图 4 菌落(A)和菌体(B)形态
Figure 4. Colonies (A) and bacterial (B) morphology

图 5 系统发育树
Figure 5. Phylogenetic tree

图 6 不同pH下CM33耐酸性
Figure 6. Acid resistance of CM33 at different pH
表 1 乳酸菌核苷降解能力分析(降解率>80%)
Table 1 Analysis of nucleoside degradation ability of lactic acid bacteria (degradation rate>80%)

注:同列不同小写字母表示数据间有显著差异(P<0.05),表2同。
表 2 乳酸菌核苷降解能力分析(降解率<80%)
Table 2 Analysis of nucleoside degradation ability of lactic acid bacteria (degradation rate<80%)





本章节筛选出具有高效降解嘌呤核苷能力的发酵粘液乳杆菌CM33,其对肌苷和鸟苷的降解率均超过99.9%,降解速率达8.33 mg·L·min。该菌株可能通过竞争性吸收机制减少机体对嘌呤核苷的吸收,从而缓解尿酸异常升高。但CM33不耐受胃酸环境(pH2.5和pH3.0),需通过微胶囊化技术提升其抗酸性,以实现肠道定植和益生功能。研究为开发降解嘌呤核苷的乳酸菌制剂提供了理论依据。

引用本文:胡旺,门光明,姜梅. 高效降解嘌呤核苷乳酸菌筛选及益生特性研究[J]. 食品工业科技,2025,46(23):221−228. doi: 10.13386/j.issn1002-0306.2025070093.
Citation:HU Wang, MEN Guangming, JIANG Mei. Screening of Lactic Acid Bacteria with High Efficiency in Degrading Purine Nucleotides and Study on Probiotic Characteristics[J]. Science and Technology of Food Industry, 2025, 46(23): 221−228. (in Chinese with English abstract). doi: 10.13386/j.issn1002-0306.2025070093.

通信作者简介

姜梅,工学博士,南京农业大学食品科学技术学院副教授、硕士生导师,研究方向涵盖食品加工技术、食品微生物与生物技术等领域。她长期从事豆制品、乳制品及肉制品加工工艺研究,聚焦功能菌资源开发及产业化应用关键技术,并在食品质量安全监管方面具有丰富经验。作为江苏省食品安全监控专家和食品生产许可专家组组长,她积极参与行业技术规范制定。截至2024年,其团队在发酵食品微生物调控领域取得新突破,相关成果发表于《南京农业大学学报》等期刊。此外,她承担多门本科生及研究生课程教学,包括《生物反应工程》《生物反应工程实验》《食品科学进展》等。
(以上信息来自网络)
往期回顾
精选文章
查看更多 →
国家重点研发计划|黑龙江八一农垦大学张东杰教授、李娟副教授:稻草秸秆纤维素基埃洛石纳米管负载牛至精油缓释抗菌膜的制备与性能分析
阅读量:18000+ · 2025-12-29
国家市场监督管理总局科技计划项目|国家市场监督管理总局田明研究员、山西大学张国华教授:澳新食品健康声称管理体系研究及启示
阅读量:12000+ · 2025-12-29
国家青年自然科学基金|南京财经大学吴思邈副教授:调味性汲取液在正渗透技术浓缩苹果汁中的研究
阅读量:9000+ · 2025-12-29
热门话题
查看更多 →

《食品工业科技》特邀主编专栏征稿
《食品工业科技》特邀主编专栏征稿:标准化赋能食品及相关产品高质量发展☚
☚
群聊:食品工业科技作者群

温
馨
提
示

我刊正式组建微信作者群,为作者提供更多的学术与论文资讯,如需进群,请联系刘老师(微信:上方二维码,电话:87244117-8062)。

版权声明




